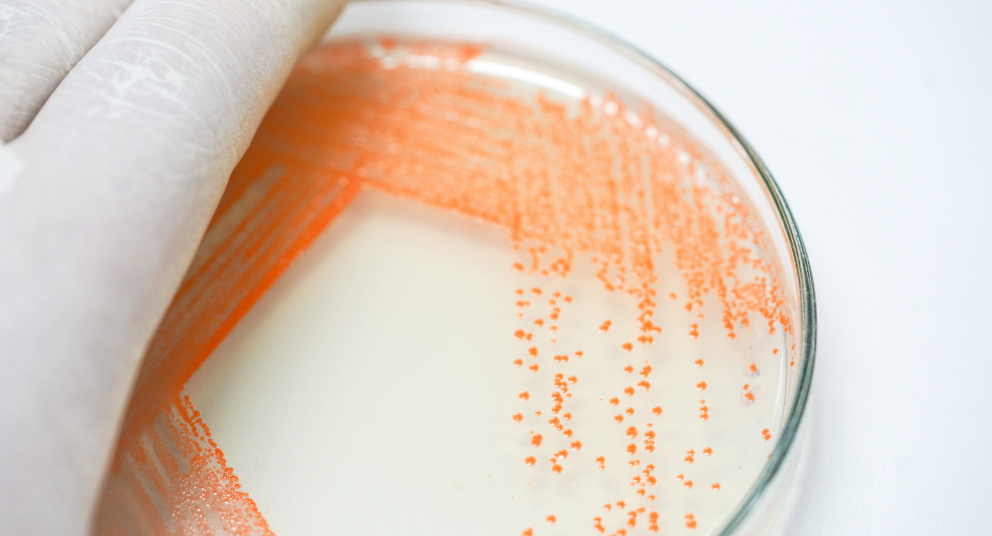

TERRENI DI COLTURA PRONTI ALL’USO
Da una solida esperienza italiana di partnership nella produzione e commercializzazione di piastre, provette e flaconi, un’amplissima scelta di terreni e di soluzioni personalizzate per il laboratorio di microbiologia.
I terreni pronti all’uso sono disponibili in piastre da 90 mm per uso clinico ed industriale, in piastre da 60 mm per analisi delle acque con tecnica di filtrazione su membrana, in piastre a due settori e inoltre in provette di diversi volumi e in flaconi di lunga stabilità.
La gamma si completa con piastre da 90 mm e piastre da contatto irradiate in doppio o triplo involucro, piastre con terreni cromogenici, piastre Compact Dry per la determinazione e la conta batterica.
La fornitura con il prodotto di Certificati di analisi attestanti la fertilità, la sterilità e la validità residua di ogni lotto elimina la necessità di procedere a questi controlli di qualità.
Contattaci
Contattaci per supporto tecnico, informazioni commerciali o richieste specifiche.
Siamo a disposizione con risposte chiare, rapide e dedicate.
